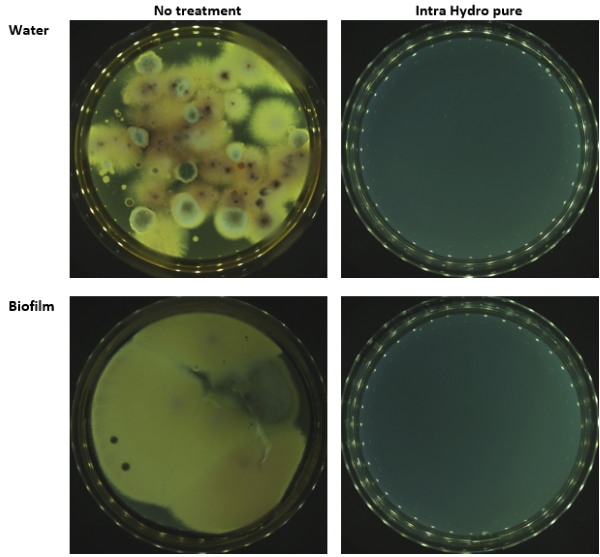
Clear visualization of biofilm removal from water lines

Step back in time with our remarkable vintage biofilm reduction potential of % polyhexanide irrigation solution collection featuring vast arrays of nostalgic images. showcasing the classic style of blue, green, and yellow. ideal for nostalgic and classic themes. Discover high-resolution biofilm reduction potential of % polyhexanide irrigation solution images optimized for various applications. Suitable for various applications including web design, social media, personal projects, and digital content creation All biofilm reduction potential of % polyhexanide irrigation solution images are available in high resolution with professional-grade quality, optimized for both digital and print applications, and include comprehensive metadata for easy organization and usage. Our biofilm reduction potential of % polyhexanide irrigation solution gallery offers diverse visual resources to bring your ideas to life. Multiple resolution options ensure optimal performance across different platforms and applications. Diverse style options within the biofilm reduction potential of % polyhexanide irrigation solution collection suit various aesthetic preferences. Our biofilm reduction potential of % polyhexanide irrigation solution database continuously expands with fresh, relevant content from skilled photographers. Regular updates keep the biofilm reduction potential of % polyhexanide irrigation solution collection current with contemporary trends and styles. Each image in our biofilm reduction potential of % polyhexanide irrigation solution gallery undergoes rigorous quality assessment before inclusion.